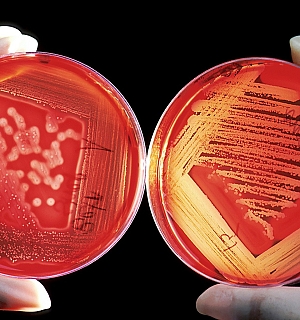

المتابعة والقطرية تقيمان لجنة طوارئ شاملة لمواجهة أزمة الكورونا...
2020/03/23 17:11

إسرائيل؛ اغلاق كامل أم الاكتفاء بالمزيد من القيود على الحركة؟
2020/03/23 16:15

الحكومة الإسبانية وكابوس فيروس كورونا: الأسوأ لم يأت بعد!
2020/03/23 11:25

مراحل انتشار فيروس كورونا من الصفر إلى الوباء
2020/03/23 09:28

اصابة سائق باص سياحي من يافة الناصرة بالكورونا
2020/03/22 21:31

عالم ضعيف أمام فيروس صغير بقلم : رشاد الشوا
2020/03/22 17:33

الصحة بغزة: إصابة اثنين بفيروس كورونا عائدين من باكستان
2020/03/22 09:03

لماذا تم نقل الأسير أيمن حاج يحيى الى المستشفى؟
2020/03/21 22:47

اسرائيل؛ ألف طبيب، وألوف الطواقم الطبية بالحجر الصحي البيتي!
2020/03/21 20:42

كيف تأكدت أن أمي قد توفيت
2020/03/21 16:00

عدوى الكورونا تصيب د. ماجد غنايم مدير قسم العظام في مستشفى بوريا
2020/03/21 15:05

كورونا يفتك في إيطاليا ويجعلها الأولى عالمياً بأعداد الوفيات...
2020/03/21 12:46

جهود ارثوذكسية لتوحيد الكنيسة
2020/03/21 10:07

الكورونا؛ تسجيل أول حالة وفاة في اسرائيل
2020/03/20 23:39

اسرائيل؛ تقييد الحركة والبقاء في البيوت وفقًا لأنظمة الطوارىء
2020/03/19 22:12

علماء روس ينجحون في فك شفرة الجينوم الكامل لفيروس كورونا من مريض...
2020/03/19 19:01

مُبادرة باسم مديرة مدرسة البيروني السيدة تهاني مرعي
2020/03/19 18:30

انحسار كورونا في الصين.. وتفشيه عالمياً
2020/03/19 11:45

البطريرك ثيوفيلوس الثالث يوجه رسالة الى أبناء محافظة بيت لحم...
2020/03/19 11:25

نادي الأسير: إدارة سجون الاحتلال تبلغ الأسرى في "مجيدو" بإصابة (4)...
2020/03/19 09:48

نهائي؛ وقف التعليم عن بُعد في اسرائيل
2020/03/18 21:52
دراسة صينية تكشف فصيلة الدم الأكثر تعرض لفيروس كورونا
2020/03/18 17:28

فيروس كورونا.. اغلبية الاصابات مصدرها المطارات
2020/03/18 13:05

اغلاق كامل وحجر بيتي للجميع؛ الوزير اردان يوصي قيادة الشرطة...
2020/03/18 12:40

بطريركية الروم الأرثوذكس المقدسية تتبرع بخمسون الف دينار أردني...
2020/03/17 20:29

محكمة الصلح تمدد اعتقال أيمن حاج يحيى لستة أيام إضافية
2020/03/17 19:47

أطباء إيطاليا يعالجون بعض الحالات المصابة بكورونا ويتركون البعض...
2020/03/17 14:39

بسبب كورونا.. الولايات المتحدة تطلق برنامجاً تحفيزياً للاقتصاد...
2020/03/17 11:15

اسرائيل؛ عمليًا اعلان حالة طوارىء.. وتحرير اغلب العمال والموظفين...
2020/03/16 22:39

هل اسرائيل ذاهبة نحو تعطيل المرافق الاقتصادية وشل البلاد...
2020/03/16 13:19

منظمة الصحة العالمية: وفاة 343 شخصاً واصابة 11 ألف بفيروس كورونا...
2020/03/16 10:12

الخبر عن مُصاب بالكورونا في الناصرة كاذب!
2020/03/15 21:40

اغلاق المسجد الأقصى كإجراء وقائي من فيروس كورونا حفاظاً على...
2020/03/15 10:50

هل نذهب الى أماكن العمل أم لا؟ مرة اخرى بلبلة وعدم وضوح!
2020/03/14 22:50

وباء الكورونا يفضح كيف نفكر ولماذا لن تقوم لنا قائمة
2020/03/14 11:01

في زمن الهزائم يمكننا أن نحقق انتصاراً
2020/03/13 21:24

الكورونا؛ اغلاق المكاتب الحكومية قريبًا واتباع نظام العمل...
2020/03/13 16:41

البساتين والتعليم الخاص: إذن مرضية ورفض الذهاب الى المدارس!
2020/03/13 16:00

الكورونا؛ اغلاق المكاتب الحكومية قريبًا واتباع نظام العمل...
2020/03/13 14:15

الجامعة العبرية "تُطفِش" للطلاب العرب من السكن، بحجة "الترميمات" !
2020/03/13 11:42

"حكومة الطوارئ" وكيف يستوي "بُعد المترين" مع استثناء البساتين...
2020/03/12 20:19

اتحاد اولياء امور الطلاب في الناصرة: تعليق الدراسة بجميع مدارس...
2020/03/12 19:14

التجمع الوطني المسيحي يجري عملية تعقيم لمسارات السائحين في القدس...
2020/03/12 17:09

المدرسة المعمدانية؛ لماذا تم استثناء أهالي الطلاب من الحجر...
2020/03/12 12:49

كيف تحافظ على نفسك من عدوى فيروس كورونا؟
2020/03/11 12:02

وزير الصحة الألماني: إغلاق حدود البلاد لم يمنع من انتشار كورونا
2020/03/11 10:58

التجمع الوطني المسيحي يطلق حملة "وقاية من فيروس كورونا" في القدس
2020/03/11 09:12

نتنياهو يعود بقوة؛ ليفي أباكسيس ستنسحب، وهي البداية!
2020/03/10 23:05

قرارات حكومية جديدة بعد ارتفاع عدد الاصابات بفيروس كورونا في...
2020/03/10 09:40

اغلاق البلاد؛ حجر صحي لكل من يدخل اسرائيل!
2020/03/09 20:10
bar_chart_4_bars اقتصاد واستهلاك

ارتفاع أسعار النفط مع ترقب التجار لأحداث...
2024/10/10 18:21
إيكونوميست: وتيرة فرار الأموال من إسرائيل...
2024/09/26 07:36
ارتفاع معدل التضخّم في إسرائيل - البندورة...
2024/09/16 08:27
إلغاء الاستثمارات في نصف شركات الهايتك...
2024/09/12 14:08bar_chart_4_bars Chefcom - شيفكم

فلافل الشمندر.. ابتكار شهيّ وغنيّ
2024/09/10 14:08
الحامض بالنعناع - عصير الصيف المنعش
2024/07/22 00:12
حلوى عيش السرايا.. سهلة وبسيطة
2024/07/18 20:48
سلطة التين المشوي مع الجرجير
2024/07/01 00:08bar_chart_4_bars فن وناس

القبض على سعد الصغير وبحوزته مواد مخدرة في...
2024/09/10 13:52
الفنانة رانيا منصور تستعيد رشاقتها بعد...
2024/08/27 09:50
اعتداء جنسي؟ إقصاء زوج هبة طوجي من لجنة...
2024/08/26 15:54







